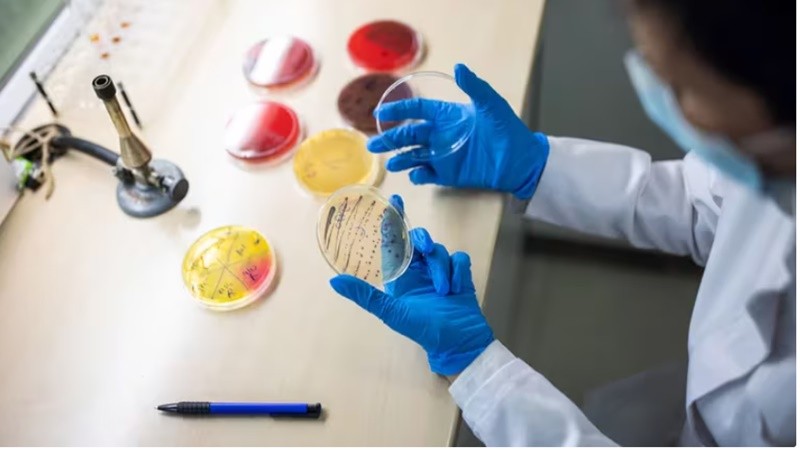

Día de la lucha contra el Síndrome Urémico Hemolítico: 9 claves para prevenir la enfermedad
El Día Nacional de la Lucha contra el Síndrome Urémico Hemolítico (SUH), que se celebra cada 19 de agosto, tiene por objetivo generar conciencia sobre esta patología que afecta, principalmente, a niños y niñas menores de 5 años. Según los expertos de Mayo Clinic, se trata de una afección que ocurre cuando los pequeños vasos sanguíneos se dañan e inflaman, provocando la formación de coágulos que pueden dañar los riñones y otros órganos, y potencialmente conducir a insuficiencia renal.
Aunque puede afectar a cualquier persona, lo cierto es que es más común en niños pequeños y generalmente se debe a infecciones por cepas específicas de la bacteria Escherichia coli (E. coli). En el marco de esta efeméride, la Sociedad Argentina de Pediatría lanzó una “campaña nacional de prevención y concientización, que se extenderá durante una semana completa de actividades y campañas informativas, jerarquizando la prevención y el seguimiento con controles periódicos”.
“La transmisión del SUH se da principalmente a través del consumo de alimentos y agua contaminados. Las carnes mal cocidas, lácteos no pasteurizados, las verduras crudas mal lavadas, la contaminación cruzada (al usar la misma superficie o utensilios para lo crudo y lo cocido), el uso de agua no potable, las manos contaminadas (contagio de persona a persona) y bañarse en aguas contaminadas son las principales vías de infección”, especificó el doctor Miguel Liern, médico pediatra y nefrólogo infantil, integrante del Comité de Nefrología de la Sociedad Argentina de Pediatría (SAP).
Por su parte, Lucas Lucarelli, médico nefrólogo, pediatra y también miembro del Comité de Nefrología de la SAP, agregó: “No existe todavía un tratamiento específico, por lo que la prevención es fundamental, así como también es crucial el seguimiento médico regular para los niños y niñas que desarrollan SUH, ya que pueden presentar complicaciones severas a largo plazo. Los controles periódicos con un nefrólogo pediátrico son esenciales para monitorear y prevenir cualquier deterioro de la salud renal”.
Fuente: INFOBAE